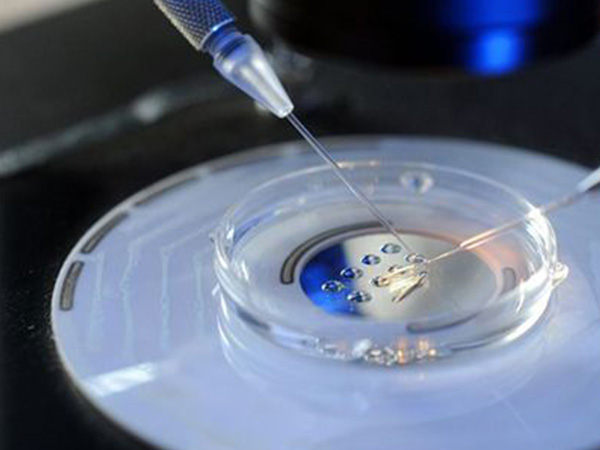

鲜胚移植第二天有姨妈感觉属正常,这些才是判断着床的依据
- 试管婴儿经验
- 2023-07-04 09:59
鲜胚移植是试管婴儿移植中重要的一环,这也是试管婴儿流程中的最后一步,通常情况下如果能够在鲜胚移植后着床就大概率表示试管已经成功了。而判断是否着床就可以根据一些症状来作为依据,比较明显的如恶心、呕吐、头晕头痛等等,通常出现这些症状的时间大约是在3-7天内,很多女性表示在鲜胚移植后的第二天有强烈的姨妈感,但这种反应属于正常现象,并不能作为判断着床的依据。
部分女性鲜胚移植后无感觉
先怀孕,后付款-出生才是硬道理47岁1个卵泡一次成功经验分享不出国做三代-疫情下的试管新对策57岁供卵试管婴儿成功经验分享
助孕交流群
方法/步骤
鲜胚在移植完成后,会经历一系列的过程才能成功着床,大致的情况是通过长时间的游动后不停地寻找着床的位置,在这个过程中在不断地进行分裂发育,直到找到合适的位置,一般情况下从鲜胚移植结束到着床需要经历的时候在一周左右,所以通常在第二天不会出现任何征兆,如果此时有腹痛或腹泻的情况,可能和自身的身体状况有关。
鲜胚移植成功后可能会腹痛
通常情况下,鲜胚从移植后到着床的这段时间内只会出现比较细微的反应,但也有部分女性会出现较为明显的症状,所以如果在移植后有类似下面这些明显的感觉,就可能表示已经成功着床了:
1.月经不来。这是一个长期的过程,只要胚胎着床了,则就不会再有生理周期,经期正常的女性可以根据自身的时间来进行推算;
2.hcg含量。这是判断鲜胚移植是否着床的重要依旧,如果hcg含量猛地增高且有翻倍的趋势,那一定的成功着床了;
3.细微的症状。常见的有乳房变胀、变软、比较容易疲惫等等,不同的人往往有不同的表现。
Tips:
其实在鲜胚移植之后有部分女性会有特定的表现症状,而绝大部分女性在没有明显症状的情况下也能着床成功,所以对于正处于鲜胚移植过程中的女性来说,不能只靠是否有症状来判断是不是着床了,一切要hcg的含量为准。
鲜胚移植不成功的两大症状
鲜胚移植后出现的各种症状往往是激素的结果,而激素是需要胚胎成功着床之后才出现的,所以如果出现了移植失败的情况则可能会表现出截然相反的现象:
移植后要一周左右时间来着床
1.腹痛。腹痛不能完全作为鲜胚移植失败的表现,相反轻微腹痛还能作为着床成功的依据,如果疼痛强烈,则表示失败了;
2.阴道出血。这里的出血往往是比较大量的,如果是少量则表示着床成功。
Tips:
无论是何种症状,都是需要等待一周左右才能作为判断依据的,如果在第二天出现姨妈感和腹痛感是不能判断出是否着床的,所以想要知道结果还应该再等待一段时间,通常情况下五天左右就能知道确切的结果了。

发表评论